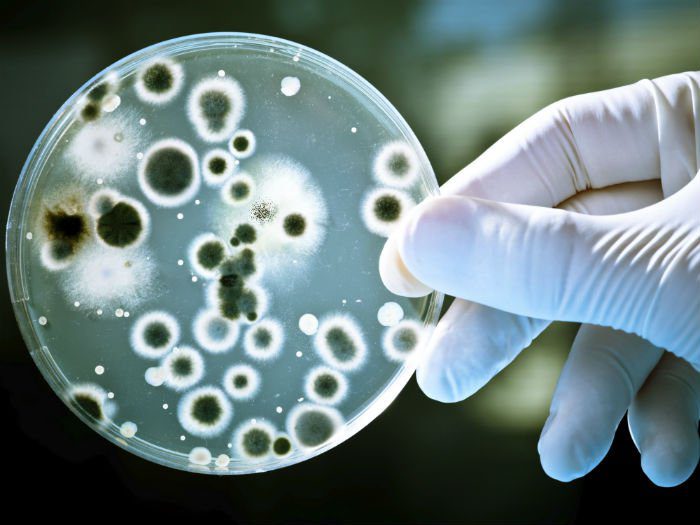

Только на основе полученных результатов врач сможет с уверенностью заявлять о хроническом пиелонефрите, о его обострении, а также рассказать пациенту, как облегчить его состояние, устранив некоторые симптомы.
При проведении лабораторных анализов мочи, при хроническом пиелонефрите устанавливается увеличенное количество белка, лейкоцитов, что характерно для заболеваний, сопровождающихся воспалительным или инфекционным процессом.
Анализ мочи по Нечипоренко позволяет установить уровень выраженности воспалительного процесса. Также обязательно проводится анализ мочи по Зимницкому, по результатам проведения которого устанавливается концентрационная способность почечных органов.
Однако удовлетвориться только результатами лабораторных исследований, конечно, нельзя, поэтому больного направляют на ультразвуковую диагностику.
УЗИ почек
При проведении УЗИ удается выявить повреждения паренхимы и оценить их степень.
Также при проведении ультразвукового исследования удается обнаружить присутствие конкрементов, провоцирующих закупорку мочевых путей.
Помимо УЗИ, показано проведение экскреторной урографии, благодаря которой удается установить уровень функционирования почечных органов.
Если имеются симптомы, указывающие на проблемы с кровообращением в почках, обязательно больного направляют на почечную ангиографию.
Для того чтобы диагностировать патологию и выяснить причину обострения требуется пройти ряд исследований, которые заключаются в следующем:
- общий анализ крови и урины;
- пробы по Зимницкому и Нечипоренко;
- преднизолоновые и пирогеналового теста;
- БАК;
- проведение рентгенологического исследования почек;
- выполнение хромоциотоскопии;
- выполнение ретроградной и выделительной пиелографии;
- исследование биоптата и биопсия;
- МРТ и КТ;
- УЗИ.
УЗИ почек — обязательное исследование при обострении патологии
Все перечисленные выше исследования помогут не только выявить причину и поставить верный диагноз, а также исключить возможные сопутствующие заболевания, которые могут отличаться схожей клинической картиной.
Для уточнения информации, позволяющей поставить диагноз пиелонефрит, используются следующие анализы и исследования:
- исследование мочевого осадка (общий анализ). В моче обнаруживается повышенное содержание лейкоцитов, вплоть до пиурии (гной в моче), бактерии, эпителиальные клетки, белок. Моча при осмотре мутная, с хлопьями и различными примесями;
- анализ мочи по Земницкому (определяет концентрационную функцию почек);
- анализ по Нечипоренко (исследуют количество лейкоцитов, эритроцитов, цилиндров в 1мкл мочи);
- общий анализ крови (в крови повышается СОЭ, количество лейкоцитов, анемия при хроническом процессе);
- бактериологическое исследование мочи (бакпосев) с целью оптимального подбора антибактериального лечения, и для его последующего контроля, недостатком метода является длительное время ожидания результата (5-7 дней);
- биохимический анализ (может увеличиваться креатинин, мочевина);
- ультразвуковой метод позволят хорошо визуализировать патологические изменения почечной паренхимы, наличие плотных включений (мочевые камни), эктопии, нарушение расположения почек, наличие гидронефроза, опухолевого процесса;
- рентгенологический метод (обзорный снимок почек) позволяет выявить мочекаменную болезнь, нарушение положения почки и другие изменения;
- компьютерная томография, как один из высокоточных методов диагностики, способен диагностировать заболевания на начальных стадиях, когда патологический процесс ещё небольшого размера и недоступен для выявления другими методами;
- как дополнительный метод, для уточнения диагноза вне обострения, возможно использование хромоцистоскопии, урографии, пиелографии;
- для диагностики осложнений используют ЭКГ метод, исследование глазного дна.
Диагностика хронического пиелонефрита должна быть комплексной. Для постановки диагноза потребуются результаты лабораторных и инструментальных исследований.
Врачи направляют пациентов для сдачи следующих лабораторных анализов:
-
ОАК. На хроническое течение заболевания будет указывать анемия, повышение количества лейкоцитов, сдвиг формулы крови влево, а также возросшая скорость оседания эритроцитов.
-
ОАМ. По результатам анализа будет выявлена щелочная среда. Моча мутная, ее плотность снижена. Возможно присутствие цилиндров, иногда определяется бактериурия, число лейкоцитов увеличено.
-
Проба Нечипоренко выявит преобладание лейкоцитов над эритроцитами, кроме того, в моче будут обнаружены активные лейкоциты.
-
Выполнение преднизолонового и пирогеналового теста, когда испытуемому вводится преднизолон и спустя определенные промежутки времени собирают несколько порций мочи.
-
Проба по Зимницкому выявит уменьшение плотности в различных порциях мочи, которые собираются на протяжении суток.
-
БАК выявит увеличенное количество сиаловых кислот, серомукоида, фибрина, мочевины.
Кроме того, для подтверждения диагноза и изучения состояния органа необходимо выполнение некоторых инструментальных обследований, выбор которых остается за врачом:
-
Выполнение обзорного рентгенологического исследования области почек. При хроническом течении заболевания почки в размерах будут уменьшены (либо, обе, либо одна).
-
Выполнение хромоциотоскопии. Если имеется хронический пиелонефрит, то врач отметит нарушение выделительной функции почек – одно или двустороннее.
-
Выполнение выделительной или ретроградной пиелографии позволит обнаружить имеющиеся деформации и патологические изменения в чашечках и лоханках органов.
-
УЗИ почек позволяет обнаружить асимметрию органов, их деформацию, неоднородность.
-
Радиоизотопное сканирование также выявляет асимметрию почек и диффузные их изменения.
-
Детальные структурные изменения органа способны обнаружить такие высокоинформативные исследования, как КТ и МРТ.
-
Биопсию почек и исследование биоптата выполняют при клинически неясных случаях заболевания.
Важно исключить такие заболевания, как амилоидоз почек, хронический гломерулонефрит, гипертонию, диабетический гломерулосклероз, которые могут давать схожую клиническую картину.
Прежде чем назначать лечение хронического пиелонефрита у женщин врач должен удостовериться в правильности предполагаемого диагноза. Обследование пациентки является обязательным условием для составления грамотной терапевтической схемы.
УЗИ почек
Проведение комплексной диагностики позволяет урологу получить развернутое представление о степени выраженности воспалительного процесса и функционировании мочевыделительной системы.
Трудность диагностики хронического пиелонефрита обусловлена многообразием клинических вариантов заболевания и его возможным латентным течением. В общем анализе мочи выявляется лейкоцитурия, протеинурия, цилиндрурия. Исследование мочи по методике Аддиса-Каковского характеризуется преобладанием лейкоцитов над другими элементами мочевого осадка. Бактериологический посев мочи способствует выявлению бактериурии, идентификации возбудителей хронического пиелонефрита и их чувствительности к антимикробным препаратам.
Для оценки функционального состояния почек применяются пробы Зимницкого, Реберга, биохимическое исследование крови и мочи. В крови обнаруживается гипохромная анемия, ускорение СОЭ, нейтрофильный лейкоцитоз. Степень нарушения функций почек уточняется с помощью проведения хромоцистоскопии, экскреторной и ретроградной урографии, нефросцинтиграфии. Уменьшение размеров почек и структурные изменения в почечной ткани выявляются по данным УЗИ, МРТ и КТ почек. Инструментальные методы объективно указывают на уменьшение размеров почек, деформацию чашечно-лоханочных структур, снижение секреторной функции почек.
В клинически неясных случаях хронического пиелонефрита показана биопсия почки. Между тем, забор в ходе биопсии непораженной почечной ткани может давать ложноотрицательный результат при морфологическом исследовании биоптата. В процессе дифференциальной диагностики исключается амилоидоз почек, хронический гломерулонефрит, гипертоническая болезнь, диабетический гломерулосклероз.
Диета и профилактика обострений пиелонефрита
Чтобы не допустить развитие болезни, проводится соответствующая профилактика обострения хронического пиелонефрита. Не рекомендуются большие физические нагрузки. Потребуется максимально исключить стрессы. Нельзя допускать переохлаждения. Запрещается работать в горячих цеха, длительное время стоять, выходить в ночные смены.
В рационе должно содержаться минимальное количество соли. Проводится выявление и лечение интеркуррентных болезней и скрытых инфекций. Периодически требуется лечение в условиях стационара.
Важна коррекция иммунитета, периодическое лечение в санаториях соответствующего профиля. Здоровый образ жизни, правильное питание, умеренные нагрузки способствуют улучшению общего состояния организма, положительно влияя, в том числе, и на почки.
При латентном хроническом варианте воспаления пациенты длительное время сохраняют трудоспособность. При других формах трудоспособность резко снижается или утрачивается. Сроки развития хронической почечной недостаточности вариабельны и зависят от клинического варианта хронического пиелонефрита, частоты обострений, степени нарушения функций почек. Гибель пациента может наступить от уремии, острых нарушений мозгового кровообращения (геморрагический и ишемический инсульт), сердечной недостаточности.
Профилактика состоит в своевременной и активной терапии острых мочевых инфекций (уретрита, цистита, острого пиелонефрита), санации очагов инфекции (хронического тонзиллита, гайморита, холецистита и др.); ликвидации местных нарушений уродинамики (удалении камней, рассечении стриктур и др.); коррекции иммунитета.
Таким образом, лечение болезни у женщин осуществляется медикаментозно, с учетом соблюдения диеты и устранения сопутствующих патологий.
Хроническое заболевание почек имеет рецидивирующий характер, поэтому для достижения стабильного результата терапия пиелонефрита проводится от нескольких месяцев до года.
Переохлаждение
Снятие воспаления и купирование симптомов – не единственная задача, стоящая перед урологом.
В большей степени лечение хронического пиелонефрита ставит перед собой цель предотвращения вероятных осложнений.
Кроме того, успешно преодолев обострение, каждая женщина должна придерживаться элементарных мер предосторожности. Без должной профилактики рецидива пиелонефрита не избежать.
Следует учесть, что любые переохлаждения служат благоприятнейшими условиями для активизации патологических процессов. Избегать нужно и респираторных заболеваний, вирусных и бактериальных инфекций, не забывая о своевременном лечении любых потенциально опасных очагов воспаления.
Клюква
В дополнение к лечению и профилактике пиелонефрита возможно применение альтернативных лекарственных средств.
Особенно полезными при патологии почек и болезненных симптомах являются травяные отвары из зверобоя, ромашки, полевого хвоща, настои из кукурузных рыльцев, клюквы, брусничных листьев, толокнянки.
Заниматься самолечением при хроническом пиелонефрите нельзя ни в коем случае. Без соответствующей терапии и профилактических мер избежать осложнений достаточно тяжело, именно поэтому в запущенных случаях единственным правильным решением становится хирургическое вмешательство.
В период ремиссии больной должен тщательно заботиться о здоровье своих зубов, носить одежду из натуральных тканей, которая не сдавливает нижнюю часть живота, избегать переохлаждений, придерживаться правильного питьевого режима, своевременно лечить инфекционные заболевания.
Наблюдаться у специалиста следует на протяжении всей жизни, поскольку отсутствие видимых симптомов при хроническом пиелонефрите не всегда говорит о том, что от него удалось избавиться. Иногда обострение может наступить даже через несколько лет после начала болезни (острой формы) или предыдущего рецидива.

При состоянии, вызываемом обострением почечного воспаления, назначают специфический стол №7, включающий такие диетические рекомендации:
- ограничение потребления кухонной соли вплоть до исключения;
- увеличивается в рационе доля растительной пищи;
- незначительно ограничиваются продукты, содержащие белок;
- абсолютно исключаются пряности, копчености, жирные бульоны;
- потребление жидкости ограничивается 1,5 л в сутки.
Соблюдение такой диеты является одновременно и профилактическим мероприятием, предупреждающим возникновение обострений заболевания. Кроме того, необходимо остерегаться значительных переохлаждений, чрезмерных физических нагрузок и стрессов, способствующих снижению сопротивляемости организма.
Чтобы предотвратить развитие обострения пиелонефрита, важно соблюдать следующие меры профилактики:
- Стараться не допускать переохлаждения и предостерегаться от респираторных заболеваний.
- Обеспечить рациональное и сбалансированное питание, ограничить употребление вредной для почек пищи (острых, соленых, маринованных и копченых продуктов).
- Соблюдать общие правила гигиены.
- Важно устранить проблемы с мочеиспусканием. Своевременно опорожнять мочевой пузырь.
- Принимать фитопрепараты или почечные чаи.
Придерживаясь этих рекомендаций, можно снизить риск развития патологии в несколько раз.
При подозрении на обострение болезни необходимо пройти медицинское исследование. После подтверждения диагноза специалист назначит соответствующее лечение. Игнорировать врачебные предписания нельзя, поскольку данное заболевание считается очень опасным и может привести к отказу почек и в результате к летальному исходу.
Терапия должна быть комплексной: медикаментозные препараты, физиопроцедуры, средства народной медицины, соблюдение диеты, санаторно-курортное лечение. Развитие обострения хронического пиелонефрита можно предупредить, придерживаясь рекомендаций относительно профилактики.
-
Профилактика больных пиелонефритом сводится к своевременному и тщательному лечению пациентов на стадии острого пиелонефрита. Такие больные должны состоять на диспансерном учете.
-
Существуют рекомендации по трудоустройству больных с хроническим пиелонефритом: пациентам не рекомендуется устраивать на предприятия, требующие тяжелого физического труда, способствующих нахождению в постоянном нервном напряжении. Важно избегать переохлаждения на рабочем месте и вне него, стоит избегать работы на ногах и в ночное время, исключена работа в горячих цехах.
-
Следует соблюдать режим питания с ограничением соли по рекомендациям врачей.
-
Успех профилактических мероприятий при вторичных пиелонефритах зависит от полноценной ликвидации причины, приведшей к развитию болезни. Важно в обязательном порядке устранить любые препятствия к нормальному оттоку мочи.
-
Важно выявление и лечение скрытых очагов инфекции и интеркуррентных болезней.
-
После выписки из стационара, больные должны быть поставлены на диспансерный учет на срок не менее одного года. Если по прошествии этого времени не выявляется бактериурия, лейкоцитурия и протеинурия, то больного с учета снимают. Если признаки заболевания сохраняются, то следует продлить срок наблюдения за такими больными до трех лет.
-
Если у больных выявлен первичный пиелонефрит, то лечение многолетнее, с периодическим помещением их в стационар.
-
Не менее важна коррекция иммунитета и поддержание его в норме. Для этого необходимо соблюдение здорового образа жизни, продолжительное пребывание на свежем воздухе, дозированные физические нагрузки по показаниям врача.
-
Пребывание в санаторно-курортных учреждениях специализированного профиля позволяет уменьшить количество обострений заболевания.
-
Отдельного внимания заслуживает профилактика заболевания у беременных женщин и детей, а также у больных с ослабленным иммунитетом.
При латентном течение болезни больные на протяжении долгого времени не утрачивают способности к труду. Иные формы пиелонефрита могут оказать существенное влияние на работоспособность человека, так как существует угроза быстрого присоединения осложнений.
Автор статьи:Лебедев Андрей Сергеевич | Врач-уролог
Образование: Диплом по специальности «Андрология» получен после прохождения ординатуры на кафедре эндоскопической урологии РМАПО в урологическом центре ЦКБ №1 ОАО РЖД (2007 г.). Здесь же была пройдена аспирантура к 2010 г.
Другие врачи
‹
5 лучших продуктов для мужской силы!
Правда ли, что нужно очищать организм? Мифы и доказанные факты!
›
Диета и профилактика обострений пиелонефрита
Правильное питание при хроническом пиелонефрите – это обязательное условие полноценного лечения. Она предусматривает исключение из рациона питания острых блюд, всех наваристых бульонов, различных приправ для усиления вкуса, а также крепкого кофе и алкоголя.
Калорийность пищи занижать не следует, в сутки взрослому человеку необходимо потреблять до 2500 ккал. Рацион должен быть сбалансирован по количеству белков, жиров и углеводов и обладать максимальным набором витаминов.
Оптимальной при хроническом пиелонефрите считается растительно-молочная диета с добавлением мяса и рыбных блюд.
Необходимо включать в ежедневный рацион разнообразные овощи: картофель, кабачки, свеклу, капусту, а также различные фрукты. Обязательно на столе должны присутствовать яйца, молочные продукты и само молоко.
При дефиците железа необходимо есть больше яблок, земляники, гранатов. На любой стадии хронического пиелонефрита рацион должен быть обогащен арбузами, дынями, огурцами, тыквой. Эти продукты обладают мочегонным эффектом и позволяют быстрее справиться с заболеванием.
Прежде чем начинать терапию хронического пиелонефрита важно отыскать провоцирующий болезнь фактор и устранить его. При необходимости больной необходимо удалить мочевые камни, новообразование и обеспечить полноценный отток мочи.
Норма потребления воды
Кроме того, не менее важной является и коррекция питьевого режима. При отсутствии отеков, повышенного артериального давления, задержки мочеиспускания женщине следует пить как можно больше жидкости.
Это позволит механическим путем воздействовать на мочевыделительную систему, вымывая с мочой патогенную микрофлору и заставляя почку работать.
Пить необходимо воду очищенную, осторожность следует соблюдать при употреблении минеральной воды. Такая жидкость обладает высоким содержанием солей натрия, способного увеличить нагрузку на ослабленный орган.
Отвар шиповника – более безопасная альтернатива минеральной воде. Не менее полезными при симптомах и лечении пиелонефрита станут витаминизированные соки, морсы, компоты. Ни в коем случае нельзя употреблять газировку, желательно отказаться от кофе и черного чая.
При хроническом пиелонефрите особенно полезен женщинам клюквенный морс, обладающий антисептическим и противоадгезивным действием, очищая внутренние почечные ткани и мочеточники.
На период лечения изменения должны затронуть и привычный стиль питания пациентки. Женщине придется пересмотреть свое повседневное меню, максимально ограничивая употребление соли, специй, приправ.
При этом упор лучше сделать на свежих овощах, фруктах, кисломолочной продукции. Потребление белковых продуктов животного происхождения желательно минимизировать, что поможет избежать усугубления симптомов.
Здоровье почек
Больным хроническим пиелонефритом особенно полезны летние бахчевые культуры, обладающие выраженным мочегонным действием. Кроме того, арбузы и дыни пополнят дефицит витаминов в организме.
Для женщин с данным недугом почек на период лечения и после него под строжайшим запретом находится алкоголь.
Мужчины любят злоупотреблять пивом, много курят – эти вредные привычки постепенно разрушают здоровье, особенно негативно сказываются на почках. Придется сделать выбор – быть здоровым или продолжать убивать свой организм.
Острый пиелонефрит характеризуется серозным или гнойным воспалением чашечно-лоханочного аппарата, в ряде случаев, с формированием гнойников и абсцессов в почке. Может быть как одно, так и двусторонее поражение. Заболевание отличается ярко выраженными симптомами. Больную беспокоит повышение температуры до высоких цифр, озноб с лихорадкой. Часто уровень температуры превышает 39 С.
Инфекционное воспаление в почке сопровождается слабостью, астенией, нарушением работоспособности. При одновременном вовлечении в процесс мочевого пузыря и мочевыводящих путей, больную беспокоят выраженные дизурические симптомы (частое дробное мочеиспускание с резью, выделение мочи каплями или малыми порциями, жжение в мочеточнике).
Хронический пиелонефрит – неспецифический процесс, при котором воспалительные изменения в большей мере затрагивают интерстициальную ткань, одновременно поражая мочевые пути. В дальнейшем иммуноопосредованный процесс воспаления может поражать клубочки почек, приводя к почечной недостаточности.
Хронический пиелонефрит у женщин протекает с обострениями, признаки которых сходны с симптомами острого пиелонефрита.
Особенностью пиелонефрита при длительном течении является деформация почки за счёт склерозирования, появление признаков вторичной артериальной гипертензии почечного генеза, развитие анемии (снижение эритроцитов, гемоглобина), появление отёков и других признаков задержки жидкости.
При исследовании биоптатов почек больных хроническим пиелонефритом обнаруживают воспалительные инфильтраты, местами чередующиеся со склеротическими изменениями интерстиция, фиброзную трансформацию клубочкового аппарата. При длительном протекании хронического пиелонефрита, почки уменьшаются в размере за счёт нефросклероза, наружная капсула деформируется, внешне её поверхность становится бугристой, рубцово- изменённой.